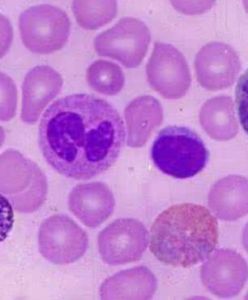
紅細胞分化因子

簡介
紅細胞分化因子 [hóng xì bāo fèn huà yīn zǐ]
[生物化學] erythroid differentiation factor
紅細胞分化因子(EDF)對小鼠紅白血病(MEL)細胞生長的抑制作用。當EDF劑量82%;在軟瓊脂上形成的集落數為照組的0.52%。同時,處於細胞周期不同時相的細胞數量發生顯著改變,Go加G1期細胞數比對照組增加55.6%,S期細胞數增加14..3%,而G2和M期細胞數則減少28.8%。此外,細胞電泳遷移率也減少到對照組的50%。以上結果說明,EDF對MEL細胞的增殖有抑制作用。
相關介紹
一種新的紅細胞分化因子
背景:紅細胞生成,即持續生成紅細胞以對抗細胞破壞。紅細胞生成是精確控制的生理機制,能給正常組織供氧產生足夠量的紅細胞,但並不產生太多的細胞而阻礙循環。紅細胞的形成發生在骨髓,是受激素即促紅細胞生成素控制的。促紅細胞生成素是紅細胞生成的主要激素性調節劑,它支持紅細胞從造血幹細胞中增殖和終末成熟。
新發明:魏茲曼研究所的研究人員鑑定了命名為Codanin-1的新型紅細胞分化因子的基因編碼。研究表明,這種蛋白參與紅細胞的分化。分化因子中的突變與先天性紅細胞生成異常性貧血(CDA)有關;CDA是後紅細胞系前體中發育不良變化相關的遺傳性紅細胞紊亂。
套用領域:A.Codamin-1蛋白能體內和體外套用,以促進紅細胞分化。B.用於涉及異常紅細胞分化疾病的基因治療,例如先天性紅細胞生成異常貧血(CDA)的基因治療。C. 先天性紅細胞生成異常貧血(CDA)的遺傳檢驗。